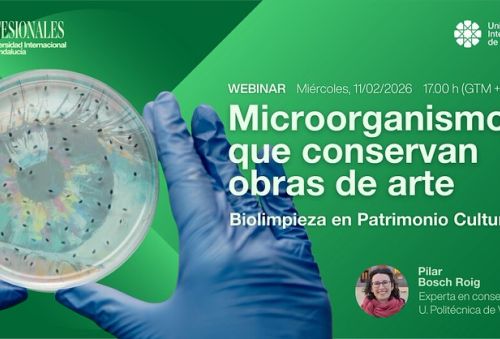

La UNIA se suma al Día de la Mujer en la Ciencia con un webinar sobre biolimpieza de obras de arte
Pilar Bosch Roig impartirá un taller práctico este miércoles 11 de febrero, dentro de del ciclo “Profesionales x Universidad Internacional de Andalucía”
La Universidad Internacional de Andalucía participa un año más en el Día de la Mujer y la Niña en la Ciencia, a través de un taller virtual sobre la biolimpieza de obras de arte que tendrá lugar mañana 11 de febrero a las 17 horas. Lo hará de la mano de Pilar Bosch Roig, profesora titular de la Universidad Politécnica de Valencia y docente en el Máster en Conservación y Restauración de Bienes Culturales (UGR-UNIA), dentro del ciclo de webinars gratuitos Profesionales.
Bajo el título Microorganismos que conservan obras de arte: biolimpieza en Patrimonio Cultural, este taller profundizará en el uso de métodos eco-sostenibles en conservación y restauración, cuáles son sus ventajas y cómo se aplica sobre las superficies artísticas. Un recorrido de carácter práctico, donde se hablará de las iniciativas más innovadoras en su campo y algunas ideas inspiradoras, para los profesionales de este sector.
Este taller, abierto al gran público, está pensado especialmente para estudiantes y egresados en ciencias sociales, humanidades digitales y en biología. También para emprendedores en el ámbito del arte y la cultura, así como personas dedicadas a la restauración o a la gestión del patrimonio.
Profesionales x UNIA
Profesionales x Universidad Internacional de Andalucía nace como un recurso de aprendizaje útil y directo, que pretende profundizar en aspectos novedosos y de gran interés en el desempeño laboral. En contraposición con el formato en auge a través de las redes sociales, con vídeos de escasa duración, este programa apuesta por exposiciones de cuarenta y cinco minutos, además de una ronda de preguntas, equilibrando el conocimiento a mostrar y el tiempo a dedicar por parte de los asistentes.
El ciclo dio comienzo el 20 de enero con el taller Patrimonio inteligente: cómo la IA redefine el acceso, la autoría y los derechos culturales impartido por la catedrática de Historia del Arte Nuria Rodríguez Ortega. Además, se ha hablado de IA y aluciaciones, con Antonio Ortiz, autor del blog Error500, y del uso de la inteligencia artificial en las industrias 4.0 y 5.0, de manos de David García Selfa, coordinador sobre la investigación en IA en el Centro de Supercomputación de Galicia (CESGA)
Dentro de la programación, el plantel de ponentes contará también con Enrique Rando, miembro del Consejo Técnico de la Agencia Digital de Andalucía, investigador y divulgador, que abordará como simular la ciberseguridad en las empresas, a través de ejercicios table-top para testar y preparar posibles amenazas digitales. El mes de febrero lo cerrarán Óscar Gómez y Carmen Márquez, premio de periodismo científico y socios de la consultora QWERTY, para hablar de cómo usar el podcast como herramienta educativa.
Más información:
https://www.unia.es/estudios-y-acceso/oferta-academica/webinars-profesionales-x-unia

La segunda semana de los Cursos de Verano de la Sede Tecnológica de Málaga aborda el puerto de Málaga, la tecnología educativa y los antibióticos
